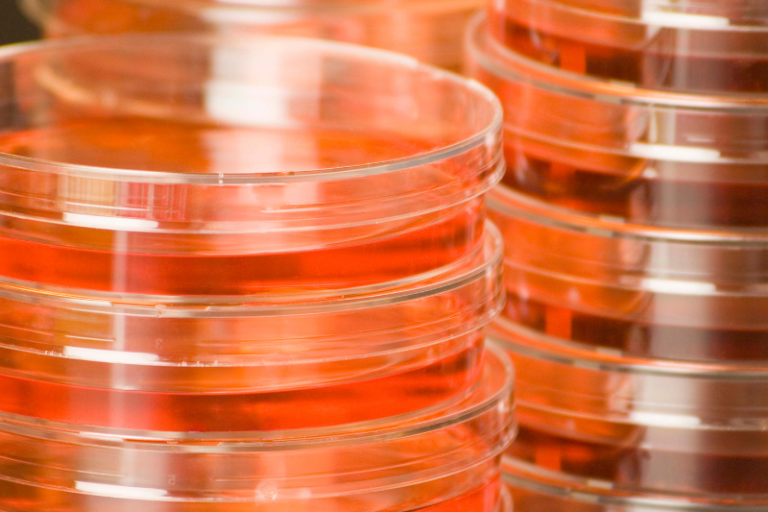

PENDING
HB 3799
Description:
Relating to the advertising and labeling of certain meat food products.
Status: Introduced 3/7/2019
Pending
PASSED
HB 1081
Relating to a study regarding the prohibition of dairy farming in certain areas of the state
Description:
Would require the Texas Animal Health Commission to conduct a study regarding the current risk level for bovine tuberculosis in certain states determined by the Commission to be infected or at high risk for bovine tuberculosis. By 9/1/2014, the Commission must submit a report of the findings to the Department of Agriculture and others listed.
Status: Effective 6/14/2013
Passed
Pass Date: 6/14/2013
HB 1643
Description:
Would add a concentrated animal feeding operations to the list of facilities that drones are prohibited from flying over.
Status: Effective 9/1/17
Passed
Pass Date: 6/15/2017
HB 1819
Relating to liability for injuring a trespassing sheep or goat
Description:
Would make a person with a fence that is insufficient who kills or wounds a head of cattle, horse, goat or sheep liable to the owner of the animal for damages.
Status: Effective 9/1/2013
Passed
Pass Date: 6/14/2013
FAILED
HB 334
Relating to the establishment of the Texas Livestock Care Standards Advisory Committee
Description:
Would establish a 16-member Texas Livestock Care Standards Advisory Committee. The committee would be required to research and develop standards governing livestock and poultry care, food safety, local food availability, food affordability, and best farm management practices for animal well-being.
Status: Introduced 11/19/2010; Died in Committee
Failed
SJR 22
Right to hunt, fish, and harvest wildlife amendment
Description:
Would amend Aricle 1, Section 34 of the Texas Constitution to include that people have the right to hunt, fish and harvest wildlife, including the use of traditioal methods, subject to laws and regulations to conserve and manage wildlife and preserve the future of hunting and fishing. Would also state that hunting and fishing are preferred methods of managing and controlling wildlife.
Status: Enrolled 5/20/2015; Died in Chamber
Failed